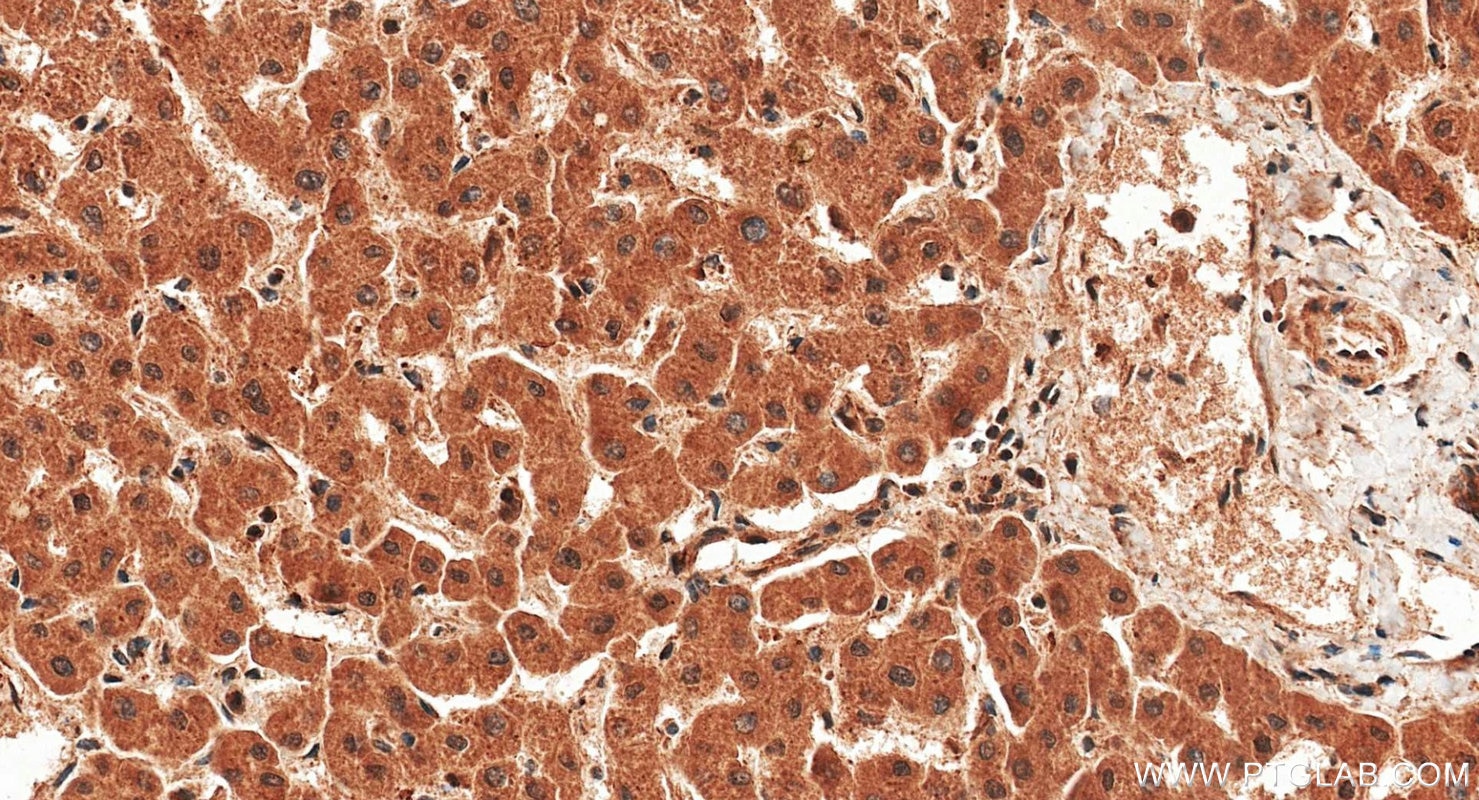
Immunohistochemistry (IHC) staining of human liver tissue using iNOS Polyclonal antibody (22226-1-AP)

Tested Applications
| Positive WB detected in | Caco-2 cells, RAW 264.7 cells |
| Positive IHC detected in | mouse liver tissue, human liver tissue Note: suggested antigen retrieval with TE buffer pH 9.0; (*) Alternatively, antigen retrieval may be performed with citrate buffer pH 6.0 |
| Positive FC (Intra) detected in | LPS treated RAW 264.7 cells |
Recommended dilution
| Application | Dilution |
|---|---|
| Western Blot (WB) | WB : 1:500-1:2000 |
| Immunohistochemistry (IHC) | IHC : 1:250-1:1000 |
| Flow Cytometry (FC) (INTRA) | FC (INTRA) : 0.40 ug per 10^6 cells in a 100 µl suspension |
| It is recommended that this reagent should be titrated in each testing system to obtain optimal results. | |
| Sample-dependent, Check data in validation data gallery. | |
Published Applications
| WB | See 161 publications below |
| IHC | See 32 publications below |
| IF | See 90 publications below |
| CoIP | See 1 publications below |
Product Information
22226-1-AP targets iNOS in WB, IHC, IF, FC (Intra), CoIP, ELISA, Cell treatment applications and shows reactivity with human, mouse samples.
| Tested Reactivity | human, mouse |
| Cited Reactivity | human, mouse, rat, chicken |
| Host / Isotype | Rabbit / IgG |
| Class | Polyclonal |
| Type | Antibody |
| Immunogen |
CatNo: Ag17567 Product name: Recombinant human NOS2 protein Source: e coli.-derived, PGEX-4T Tag: GST Domain: 1-190 aa of BC130283 Sequence: MACPWKFLFKTKFHQYAMNGEKDINNNVEKAPCATSSPVTQDDLQYHNLSKQQNESPQPLVETGKKSPESLVKLDATPLSSPRHVRIKNWGSGMTFQDTLHHKAKGILTCRSKSCLGSIMTPKSLTRGPRDKPTPPDELLPQAIEFVNQYYGSFKEAKIEEHLARVEAVTKEIETTGTYQLTGDELIFAT Predict reactive species |
| Full Name | nitric oxide synthase 2, inducible |
| Calculated Molecular Weight | 1153 aa, 131 kDa |
| Observed Molecular Weight | 110-130 kDa, 65-70 kDa |
| GenBank Accession Number | BC130283 |
| Gene Symbol | iNOS |
| Gene ID (NCBI) | 4843 |
| RRID | AB_2879038 |
| Conjugate | Unconjugated |
| Form | Liquid |
| Purification Method | Antigen affinity purification |
| UNIPROT ID | P35228 |
| Storage Buffer | PBS with 0.02% sodium azide and 50% glycerol, pH 7.3. |
| Storage Conditions | Store at -20°C. Stable for one year after shipment. Aliquoting is unnecessary for -20oC storage. 20ul sizes contain 0.1% BSA. |
Background Information
NOS2, also named as iNOS and NOS2A, produces nitric oxide (NO) which is a messenger molecule with diverse functions throughout the body. NO is a reactive free radical which acts as a biologic mediator in several processes, including neurotransmission, antimicrobial and antitumoral activities. NOS2 is a nitric oxide synthase which is expressed in liver and is inducible by a combination of lipopolysaccharide and certain cytokines. iNOS has a very short half-life due to rapid degradation by calpain. iNOS monomer is a direct substrate of calpain I and can be cleaved by calpain I at the canonical CaM-binding site(503-532aa) of iNOS, and then a ~70kD band can be detected by western (PMID:11786228).
Protocols
| Product Specific Protocols | |
|---|---|
| FC protocol for iNOS antibody 22226-1-AP | Download protocol |
| IHC protocol for iNOS antibody 22226-1-AP | Download protocol |
| WB protocol for iNOS antibody 22226-1-AP | Download protocol |
| Standard Protocols | |
|---|---|
| Click here to view our Standard Protocols |
Publications
| Species | Application | Title |
|---|---|---|
Carbohydr Polym Chitosan-based adhesive patch with anti-inflammatory, pro-healing, and immunomodulatory properties for dural defect repair | ||
Mol Ther Epsin1-mediated exosomal sorting of Dll4 modulates the tubular-macrophage crosstalk in diabetic nephropathy | ||
Theranostics Multifunctionally disordered TiO2 nanoneedles prevent periprosthetic infection and enhance osteointegration by killing bacteria and modulating the osteoimmune microenvironment | ||
Proc Natl Acad Sci U S A Sleep deficiency exacerbates periodontal inflammation via trigeminal TRPV1 neurons | ||
Mater Today Bio Hyaluronic acid-anchored nanoparticles co-delivering emodin and siRNA confers protection against rheumatoid arthritis via macrophage polarization | ||
J Nanobiotechnology Injectable photocrosslinking spherical hydrogel-encapsulated targeting peptide-modified engineered exosomes for osteoarthritis therapy |